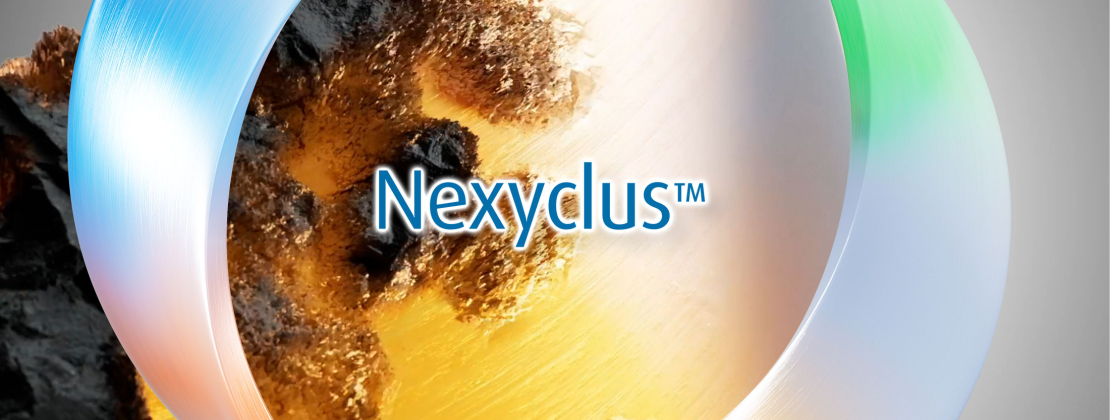
Umicore MDS - Nexyclus™ - vollständig recycelte Edelmetallbeschichtung - Gold, Silber, Platin, Palladium und Rhodium

Umicore führt das weltweit umfangreichste Angebot an recycelten Edelmetallen ein
Dank der weltweit führenden Position der Umicore-Gruppe in der Metallrückgewinnung können wir Ihnen heute unter dem Markennamen Nexyclus™ das global umfassendste Sortiment an vollständig recycelten Edelmetallen anbieten. Damit tragen wir nicht nur dazu bei, der weltweiten Ressourcenknappheit insbesondere bei den Platingruppenmetallen (PGM) entgegenzuwirken, sondern ermöglichen Ihnen vor allem eine verantwortungsbewusste Edelmetallbeschichtung - zur Unterstützung Ihrer Nachhaltigkeitsziele.

Mit Nexyclus™ investieren Sie in Beschichtungen, die einen reduzierten CO2-Fußabdruck aufweisen und verantwortungsvoll gewonnen werden

Mit Nexyclus™ garantieren wir Ihnen 100 % hochwertige recycelte Edelmetalle aus zuverlässigen Quellen, die unseren strengen Richtlinien für verantwortungsbewusste Beschaffung entsprechen. Sie haben die Wahl zwischen verschiedenen Angeboten, die sich in den Chain-of-Custody (CoC) Zertifikaten und dem Prozessablauf unterscheiden. Selbstverständlich werden alle unsere Nexyclus™-Zertifikate von unabhängigen Wirtschaftsprüfern verifiziert*.

Zertifikat 1
Materialtrennung
Dieses Zertifikat ist ein Transferdokument, das automatisch jeder Lieferung von CoC-Recyclingprodukten beiliegt. Es ist für CoC-recyceltes Gold, Silber, Platin und Palladium erhältlich und kann nur ausgestellt werden, wenn es mit physischen CoC-Metalleinheiten verknüpft ist, die von autorisierten Standorten raffiniert wurden.
Der Responsible Jewellery Council, London, (RJC) ist die weltweit führende Organisation zur Festlegung von Nachhaltigkeitsstandards für die Schmuck- und Uhrenindustrie. In Anbetracht der Beschränkungen, die der RJC-Standard für zulässige recycelte Materialien festlegt, bietet das RJC-CoC-Zertifikat die größtmögliche Transparenz für recycelte Edelmetalle, die wir anbieten können.
Dies erfordert eine strikte Trennung der gesamten Recycling- und Produktionsanlage für CoC-Produkte. Innerhalb dieser getrennten Ströme werden förderfähige CoC-Materialien aus verschiedenen Quellen gemischt, da sie denselben definierten Standard haben.
Das RJC-CoC-Zertifikat wird durch das CoC-Transferdokument dargestellt, das mit jedem von Umicore angebotenen CoC-Produkt geliefert wird und die RJC-Definition von Recyclingmaterial verwendet.
Die Wirtschaftsprüfungsgesellschaft KPMG wurde mit der Prüfung und Zertifizierung der Einhaltung des RJC-CoC durch Umicore beauftragt.
Merkmale
- Hohe Rückverfolgbarkeit: das Dokument ist mit einer entsprechenden physischen Menge eines CoC-Produkts aus CoC-recyceltem Edelmetall verbunden
- Umicore zertifiziertes Recyclingmaterial
- Verantwortungsvolle Beschaffung in Übereinstimmung mit RJC und LBMA/LPPM/RMI
- Veredelung unter anspruchsvollen technologischen und EHS-Bedingungen, ISO-zertifizierte Standorte und Prozesse

Zertifikat 2
Massenbilanz
Dieses Zertifikat, das für Silber, Gold, Platin, Palladium und Rhodium erhältlich ist, kann nur ausgestellt werden, wenn es an physische Metalleinheiten gebunden ist, die von Umicore raffiniert wurden.
Massenbilanz bedeutet, dass sowohl Primär- als auch Recyclingmaterialien in einem Prozess gemeinsam verarbeitet werden. Dabei wird der Anteil des Recyclingmaterials in einer rollierenden Bilanz erfasst und einem Äquivalent der produzierten raffinierten Metalle zugeordnet. Dadurch erhält diese äquivalente Menge den 100 % recycelt Status. Dies können wir dank unserer weltweit anerkannten Expertise bei der Probenahme und Prüfung sowie einer strengen Metallbuchhaltung garantieren.
Die Massenbilanzzertifikate werden von Umicore unter Verwendung der ISO14021-Definition von Recyclingmaterial angeboten.
Die Massenbilanz ist einer der in ISO22095.2020 beschriebenen Chain-of-Custody-Standards. Die Wirtschaftsprüfungs- und Beratungsgesellschaft PwC wird beauftragt, diese Lösung zu prüfen und zu zertifizieren.
Merkmale
- Hohe Rückverfolgbarkeit: Das Zertifikat ist mit einer entsprechenden physischen Menge an raffiniertem Edelmetall von Umicore verknüpft
- Umicores zertifiziertes Recyclingmaterial
- Verantwortungsvolle Beschaffung in Übereinstimmung mit LBMA/LPPM/RMI
- Veredelt unter anspruchsvollen technologischen und EHS-Bedingungen, ISO-zertifiziert

Zertifikat 3
Book & Claim
Dieses Zertifikat, das für Silber, Gold, Platin, Palladium und Rhodium erhältlich ist, verknüpft mit einer Metalltransaktion von Umicore an den Begünstigten des Zertifikats. Es funktioniert im Wesentlichen wie ein durch Metalltransaktionen abgesichertes Book & Claim-Zertifikat.
Die Verfügbarkeit von Book & Claim-Zertifikaten korreliert mit den Produktionsmengen von Umicore. Diese Zertifikate sind jedoch nicht direkt an den physischen Fluss von raffinierten Edelmetallen aus unseren Produktionsanlagen gebunden. Stattdessen können sie mit Edelmetallen gleichwertiger Qualität in Verbindung gebracht werden, die verantwortungsvoll von anderen Raffinerien bezogen werden und sich derzeit in unserem Besitz befinden.
Diese Lösung ist für nicht-physische Edelmetalltransaktionen von entscheidender Bedeutung, da sie die verantwortungsvolle und nachhaltige Beschaffung dieser Metalle weiter verbessert.
Über Book & Claim werden außerdem die Transaktionen abgebildet, in welchen Edelmetall nicht in reiner Form an den Endkunden geliefert werden, sondern über weitere Fertigungsschritte zu hochwertigen Salzen und Lösungen für die Galvanotechnik weiterverarbeitet werden.
Die Book & Claim-Zertifikate werden von Umicore unter Verwendung der ISO14021-Definition für recyceltes Material angeboten.
Book & Claim ist einer der in ISO22095.2020 beschriebenen Chain-of-Custody-Standards und die Wirtschaftsprüfungs- und Beratungsgesellschaft PwC wird mit der Prüfung und Zertifizierung dieser Lösung beauftragt.
Merkmale
- Hohe Flexibilität: kein obligatorischer physischer Transport von Metall
- Umicores zertifiziertes Recyclingmaterial
- Verantwortungsvolle Beschaffung in Übereinstimmung mit LBMA/LPPM/RMI
- Veredelt unter anspruchsvollen technologischen und EHS-Bedingungen, ISO-zertifiziert

Weitere Informationen zu Nexyclus™

Sobald das Zertifikat ausgestellt ist, hat es kein Verfallsdatum mehr, da das Metall sowohl kurzfristig für Anwendungen genutzt als auch langfristig zu Anlagezwecken gelagert werden kann.

Die recycelten Metalle von Nexyclus™ erfüllen dieselben hochwertigen technischen Spezifikationen wie die für raffiniertes Primärmetall.

Das Umicore Nexyclus™-Zertifikat gilt nur für die Verwendung durch den direkt begünstigten Käufer der Nexyclus™-Metalleinheiten. Das Umicore Nexyclus™-Zertifikat darf ohne schriftliche Genehmigung von Umicore nicht auf einen nachgelagerten Käufer übertragen werden.
Kompetente Beratung von Anfang an für einen reibungslosen Übergang hin zu einer verantwortungsvollen Beschichtung
Lassen Sie uns gemeinsam ausloten, welche Nexyclus™-Variante für Sie die Richtige ist - gemeinsam finden wir das optimale Modell, das natürlich bei sich ändernden Anforderungen jederzeit wieder angepasst werden kann.
Wir richten uns ganz nach Ihren Bedürfnissen und freuen uns, Sie auf dem Weg zu einer qualitätsbewussten, nachhaltigen und verantwortungsvollen Beschichtung zu unterstützen.

Andrea Grau
Leiterin Vertrieb Europa
andrea.grau@eu.umicore.com
Teams Chat starten
+49 7171 607 229 (Büro)
* Die Wirtschaftsprüfungs- und Beratungsgesellschaft PwC wird ab dem Berichtszeitraum 2024 einen Bericht zur begrenzten Sicherheit gemäß ISAE 3000 zu den Nexyclus™-Zertifikaten erstellen. KPMG ist Wirtschaftsprüfer von Umicores Jewelry & Industrial Metals und ist sowohl von der London Bullion Market Association (LBMA) als auch vom Responsible Jewellery Council (RJC) autorisiert, Zertifizierungsprüfungen gemäß international anerkannten Standards und Rahmenwerken wie z.B. innerhalb der OECD und der UN durchzuführen.

Zu dieser Seite passende Websiteinhalte